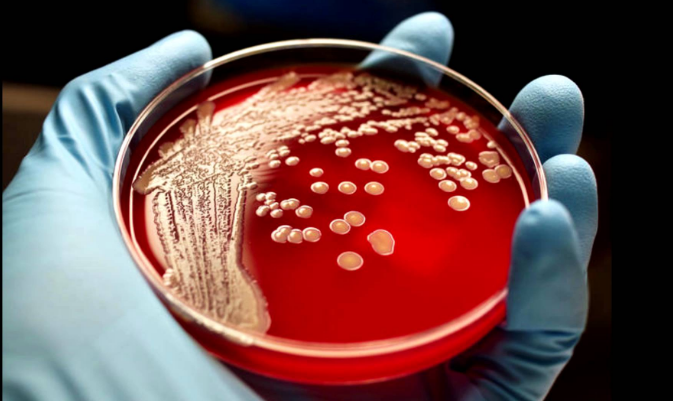

According to the "Review on Antimicrobial Resistance" survey, drug-resistant infections represent one of the greatest threats to mankind. There are fears that pandemics will cease the world as antibiotics are losing their effectiveness.
The study also involved a well-known economist Jim O'Neill. He warned that the world has witnessed the alarming increase in superinfection, reluctant to treatment and prevention.
"Even today, 700 thousand people die from resistant infections each year. Antibiotics are a special category of antimicrobial agents that underlie modern medicine as we know it. If they lose their effectiveness, key medical procedures may be too hazardous. Most direct and indirect effects of drug resistance will hit people in low- and middle-income countries", - he said.
Jim O'Neill is known as the economist who coined the term "BRIC" in 2001. It combined new economic heavyweights - Brazil, Russia, India and China.
According to O'Neill, since the preparation of the review in 2014, the problem killed more than 1 million people.
At the same time, "the tragic loss of human life" has a "real economic value, which will continue to grow, if the infections’ resistance to drugs is not overcome."
It is estimated the superbugs problem will be taking 10 million lives a year by 2050, and the economy will lose up to $ 100 trillion. All of this will happen if the decision to slow down the growth of drug resistance is not found in the near future.
O'Neill noted that many of the most pressing problems with superbugs, are economic, so it is necessary to involve those who are versed in macroeconomic issues and the global economy.
"Now for me it is clear, as it was to scientists for a long time, that the fight against antimicrobial resistance is absolutely necessary. To do this, we need to regard the problem as an economic and safety threat, to recognizing it, making it paramount to Heads of State, Ministers of Finance, Ministers of Agriculture and, of course, health Ministers"- he added.
The report assumes that global action against antimicrobial resistance will be worth up to $ 40 billion over ten years. The report calls on governments around the world to act and to invest now in order to avoid possible losses of $ 100 trillion due to "inactivity".
It is expected that the problem can be overcome by increasing public awareness, improved surveillance of drug use, improve sanitation worldwide. There is also the need to reduce pollution, and introduce methods of rapid diagnosis and development of new vaccines.
Britain and China have already agreed to contribute $ 72 million in a new "Global Innovation Fund", which will deal with the superbugs problem.
source: cnbc.com
The study also involved a well-known economist Jim O'Neill. He warned that the world has witnessed the alarming increase in superinfection, reluctant to treatment and prevention.
"Even today, 700 thousand people die from resistant infections each year. Antibiotics are a special category of antimicrobial agents that underlie modern medicine as we know it. If they lose their effectiveness, key medical procedures may be too hazardous. Most direct and indirect effects of drug resistance will hit people in low- and middle-income countries", - he said.
Jim O'Neill is known as the economist who coined the term "BRIC" in 2001. It combined new economic heavyweights - Brazil, Russia, India and China.
According to O'Neill, since the preparation of the review in 2014, the problem killed more than 1 million people.
At the same time, "the tragic loss of human life" has a "real economic value, which will continue to grow, if the infections’ resistance to drugs is not overcome."
It is estimated the superbugs problem will be taking 10 million lives a year by 2050, and the economy will lose up to $ 100 trillion. All of this will happen if the decision to slow down the growth of drug resistance is not found in the near future.
O'Neill noted that many of the most pressing problems with superbugs, are economic, so it is necessary to involve those who are versed in macroeconomic issues and the global economy.
"Now for me it is clear, as it was to scientists for a long time, that the fight against antimicrobial resistance is absolutely necessary. To do this, we need to regard the problem as an economic and safety threat, to recognizing it, making it paramount to Heads of State, Ministers of Finance, Ministers of Agriculture and, of course, health Ministers"- he added.
The report assumes that global action against antimicrobial resistance will be worth up to $ 40 billion over ten years. The report calls on governments around the world to act and to invest now in order to avoid possible losses of $ 100 trillion due to "inactivity".
It is expected that the problem can be overcome by increasing public awareness, improved surveillance of drug use, improve sanitation worldwide. There is also the need to reduce pollution, and introduce methods of rapid diagnosis and development of new vaccines.
Britain and China have already agreed to contribute $ 72 million in a new "Global Innovation Fund", which will deal with the superbugs problem.
source: cnbc.com